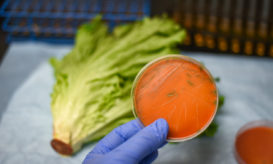

ECDC: Οι τροφικές δηλητηριάσεις σαρώνουν την Ευρώπη – Εκατοντάδες κρούσματα στην Ελλάδα
Ανησυχητικά ευρήματα νέας έκθεσης. Αυξάνονται δραματικά και τα σοβαρά περιστατικά που χρειάζονται νοσοκομείο.

Ανησυχητικά ευρήματα νέας έκθεσης. Αυξάνονται δραματικά και τα σοβαρά περιστατικά που χρειάζονται νοσοκομείο.

E.coli, λιστέρια, σαλμονέλα. Και από την άλλη πλευρά, μπιφτέκια, έτοιμες σαλάτες, έτοιμα μείγματα για παρασκευή ζύμης, αυγά, αλλαντικά και...

Έχουν νοσήσει 57 άνθρωποι σε 18 αμερικανικές πολιτείες. Ανακλήθηκαν δεκάδες προϊόντα από την αγορά.

Πώς μπορούμε να είμαστε σίγουροι ότι δεν διατρέχουμε κίνδυνο

Υπενθυμίζεται ότι, την περασμένη βδομάδα ο ΕΦΕΤ είχε προχωρήσει στην ανάκληση καπνιστής πέστροφας, στην οποία είχε βρεθεί ο ίδιος...

Διαπιστώθηκε η παρουσία του παθογόνου μικροοργανισμού Listeria monocytogenes

Πού βρίσκεται το συγκεκριμένο βακτηρίδιο, γιατί δεν είναι ακίνδυνα ούτε τα vegan προϊόντα

Με απόφαση του ΕΦΕΤ ανακαλούνται τρία προϊόντα

Σε πολλές περιπτώσεις καταγράφονται συρροές κρουσμάτων. Πόσοι άνθρωποι αρρώστησαν το 2022.

Η λιστερίωση είναι μια ασθένεια που προκαλείται από την κατανάλωση τροφών μολυσμένων από τα βακτήρια Listeria monocytogenes.
Η λιστερίωση είναι μια σοβαρή λοίμωξη που συνήθως προκαλείται από την κατανάλωση τροφίμων μολυσμένων με το βακτήριο Listeria monocytogenes...

Το κοτόπουλο είναι ένα από τα συνηθέστερα είδη κρέατος, που καταναλώνουμε σε κάθε σπίτι.

Η λοίμωξη από λιστέρια είναι μια τροφική βακτηριακή ασθένεια που μπορεί να αποβεί πολύ σοβαρή για τις έγκυες γυναίκες...

Με αφορμή το σημερινό doodle της Google για την Marie Harel, τη γυναίκα που ανακάλυψε το τυρί καμαμπέρ (Camembert),...

Ο αρμόδιος φορέας ελέγχου αγροτικών και κτηνοτροφικών προϊόντων στη Ρωσία, Rosselkhoznadzor, επέβαλε σήμερα απαγόρευση στις εισαγωγές πουλερικών από μια...